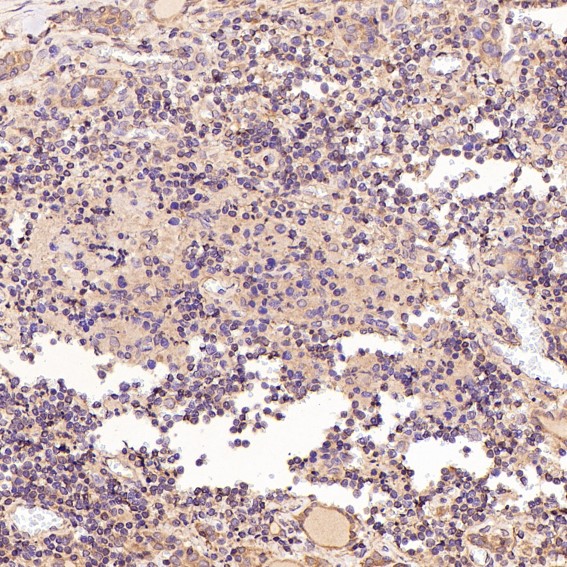

Bcl-2 Antibody (CY6717)
References (5)
UniProt:P10415
Application:WB,IHC,ICC/IF,FC
Reactivity:Human,Mouse
Source:Rabbit mAb
Bcl-2 Antibody (CY6717)
UniProt:P10415
Application:WB,IHC,ICC/IF,FC
Reactivity:Human,Mouse
Source:Rabbit mAb
References(5)
http://www.abways.cn/showproduct.asp?cid=CY6717
Bcl-2 Antibody (CY5032)
References (18)
UniProt:P10415
Application:WB,IHC,ICC/IF,IP,FC
Reactivity:Human
Source:Rabbit mAb
Bcl-2 Antibody (CY5032)
UniProt:P10415
Application:WB,IHC,ICC/IF,IP,FC
Reactivity:Human
Source:Rabbit mAb
References(18)
http://www.abways.cn/showproduct.asp?cid=CY5032
< Prev1Next >

销售咨询
销售咨询 一键电话
一键电话